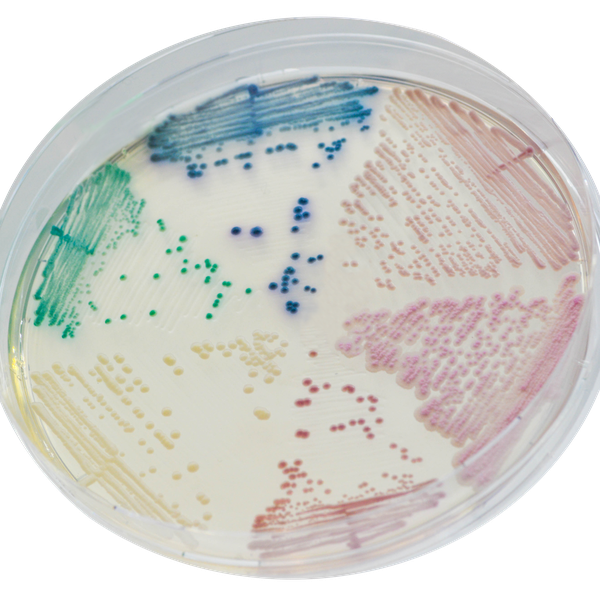
CHROMagar™ Candida

Colonies Appearance

Candida albicans
green

Candida glabrata
mauve

Candida tropicalis
metallic blue

Candida krusei
pink, fuzzy
Performance
Performance
Perhaps as a result of progress in medical therapy with a related decrease in patient resistance and increase in the number of susceptible hosts, the incidence of bloodstream Candida infections rose through the 1990s but has stabilised in recent years. More commonly, Candida species are involved in superficial oropharyngeal and urogenital infections particularly for immuno-depressed people such as the elderly and AIDS victims. “Early diagnosis is essential for early effective management of the patients.” (WHO Guidelines on Standard Operating Procedures for Laboratory Diagnosis of HIV-Opportunistic Infections). Although C. albicans remains the major species involved, other types such as C. tropicalis,
C. krusei or C. glabrata have increased proportionately as new antifungal agents have worked very effectively against C. albicans. This shows the importance of an accurate detection for a proper antifungal therapy choice.
Intended Use :
CHROMagar™ Candida is a selective chromogenic culture medium intended for use in the qualitative direct detection, differentiation and presumptive identification of Candida species. The test is performed with swabs from skin, throat, ears and vaginal specimens as well as sputum, urine and stools samples, in parallel to cultures on Sabouraud agar, to aid in the Candidiasis diagnosis. Results can be interpreted after 20-48 h of aerobic incubation at 35-37 °C.
Further microbiological testing or epidemiological typing are needed. A lack of growth or the absence of colonies on CHROMagar™ Candida does not preclude the presence of Candida. CHROMagar™ Candida is not intended to diagnose infection nor to guide nor monitor treatment for infections.
1. High contrast: Intense colony colouration helping to differentiate species and mixed cultures.

2. Fast: 20 -48 h incubation.
5. Less workload: With traditional media such as Sabouraud agar, identification of mixed cultures is difficult, whereas CHROMagar™ Candida, just by the colour of the colony, will instantly differentiate various Candida species and help locating their colonies in mixed colonies.
3. Panoramic view: Panoramic view of the Candida population mix with the ability to detect major species but also the presence of minor populations.
Composition

Technical Documents
Scientific Publications
2023
Thymoquinone Antifungal Activity against Candida glabrata Oral Isolates from Patients in Intensive Care Units—An In Vitro Study
📄 Publication2023
Effect of Antimicrobial Photodynamic Therapy, using Toluidine blue ondual-species biofilms of Candida albicans and Candida krusei
📄 Publication2023
Fungal Spectrum and Susceptibility Against Nine Antifungal Agents in 525 Deep Fungal Infected Cases
📄 Publication2023
Identification of Candida Species Associated with Blood Infection by Multiplex PCR and Phenotypic Characteristics
📄 Publication2023
Usefulness of Chromogenic Media with Fluconazole Supplementation for Presumptive Identification of Candida auris
📄 Publication2023
Effects of Candidalysin Derived from Candida albicans on the Expression of Pro-Inflammatory Mediators in Human Gingival Fibroblasts
📄 Publication2022
Candida guilliermondii as an agent of postpartum subacute mastitis in Rio de Janeiro, Brazil: Case report
📄 Publication2018
Assessment of Identification Methods for Candida auris in Microbiology Laboratories in British Columbia
📄 Publication2017
Prevalence of Candiduria in Diabetic Patients attending the Bafoussam Regional Hospital (West Cameroon) and Antifungal Susceptibility of the Isolates
📄 Publication2017
An in vitro study of isolation of candidal strains in oral squamous cell carcinoma patients undergoing radiation therapy and quantitative analysis of the various strains using CHROMagar
📄 Publication2017
Evaluation of CHROMagar Candida in the rapid identification of medically important species of Candida
📄 Publication2017
Comparison of CHROMagar, polymerase chain reaction-restriction fragment length polymorphism and polymerase chain reaction-fragment size for the identification of Candida species
📄 Publication2016
CHROMagar as a primary isolation medium for rapid identification of Candida and its role in mixed Candida infection in sputum samples
📄 Publication2016
Evaluation of Diagnostic Efficacy of CHROMagar Candida for Differentiation and Identification of Common Candida Species
📄 Publication2015
Colonization and antifungals susceptibility patterns of Candida species isolated from hospitalized patients in ICUs and NICUs
📄 Publication2015
Utility of Chromagar Medium for Antifungal Susceptibility Testing of Candida Species Against Fluconazole and Voriconazole in Resource Constrained Settings
📄 Publication2015
Routine identification and mixed species detection in 6,192 clinical yeast isolates
📄 Publication2014
Speciation of Candida species isolated from clinical specimens by using Chromagar and conventional methods
📄 Publication2013
Epidemiology, Antifungal Susceptibility and Pathogenicity of Candida africana Isolates from the United Kingdom
📄 Publication2013
Salivary Candida species carriage patterns and their relation to caries experience among Yemeni children
📄 Publication2013
Evaluation of chromogenic media and seminested PCR in the identification of Candida species
📄 Publication2012
Identification of Candida Species Screened from Catheter Using Patients with PCR-RFLP Method
📄 Publication2011
Comparación entre métodos convencionales, ChromAgar Candida® y el método de la PCR para la identificación de especies de Candida en aislamientos clínicos
📄 Publication2011
Characteristics of growth of yeasts and yeast-like fungi on chromogenic medium CHROMagar™ Candida (GRASO)
📄 Publication2011
Do incubation temperature, incubation time and carbon dioxide affect the chromogenic properties of CHROMagar?
📄 Publication2010
Evaluation of four chromogenic media for presumptive identification and differentiation of yeasts
📄 Publication2010
Use of CHROMagar Candida for the presumptive identification of Candida species directly from clinical specimens in resource-limited settings
📄 Publication2010
Comparacion entre metodos convencionales, CHROMagar Candida y el método de la PCR para la idenfificacion de especies de Candida en aislamientos clinicos
📄 Publication2007
Efficacy of Chromogenic Candida Agar for isolation and presumptive identification of pathogenic yeast species
📄 Publication2007
Sensibilidad a fluoconazol y voriconazol de aislamientos de Candida spp. obtenidos de mucosa oral de patientes con sida
📄 Publication2006
The evaluation of CHROMagar Candida as an isolation medium for identification of Candida species isolated from different clinical specimens
📄 Publication2005
Evaluación del medio cromógeno CHROMagar CandidaTM para la identificación de levaduras de interés médico
📄 Publication2004
Evaluation of biochemical and serological methods to identify and clustering yeast cells of oral Candida species by CHROMagar test SDS-page and Elisa
📄 Publication2003
Detection of fluconazole-resistant isolates of Candida glabrata Detection of fluconazole-resistant isolates of Candida glabrata by using an agar screen assay
📄 Publication2002
Replacement of Candida albicans with Candida dubliniensis in human immunodeficiency virus-infected patients with oropharyngeal candidiasis treated with fluconazole
📄 Publication2002
Case report : Candida glabrata oropharyngeal candidiasis in patients receiving radiation treatment for head and neck cancer
📄 Publication2002
Persistence of Pigment Production by yeast isolates grown on CHROMagar Candida medium
📄 Publication2001
A Comparison of Methods for Yeast Identification Including CHROMagar Candida, Vitek System YBC and a Traditional Biochemical Method
📄 Publication1999
Simple, reliable, and cost-effective yeast identification scheme for the clinical laboratory
📄 Publication1999
Evaluation of CHROMagar Candida for rapid screening of clinical specimens for Candida species
📄 Publication1998
Evaluation of CHROMagar Candida for Presumptive Identification of Clinically Important Candida Species
📄 Publication1998
Candida species from genital sites: their identification and susceptibility to fluconazole
📄 Publication1998
Diferenciacion e identificacion presuntiva rapida de levaduras con el medio CHROMagar Candida
📄 Publication1998
An evaluation of the cost-effectiveness of using CHROMagar for yeast identification in a routine microbiology laboratory
📄 Publication1998
Detection of Candida dubliniensis in oropharyngeal samples from human immunodeficiency virus-infected patients in North America by primary CHROMagar Candida screening and susceptibility testing of isolates
📄 Publication1998
Identificacion de levaduras de interes clinico en el medio de cultivo CHROMagar Candida
📄 Publication1997
Molecular and phenotypic analysis of Candida dubliniensis : a recently identified species linked with oral candidosis in HIV-infected and AIDS patients
📄 Publication1997
Use of specialised isolation media for recognition and identification of Candida dubliniensis isolates from HIV-infected patients
📄 Publication1996
Application of CHROMagar Candida for rapid screening of clinical specimens for Candida albicans, Candida tropicalis, Candida krusei, and Candida (Torulopsis) glabrata
📄 Publication1996
Routine use of CHROMagar Candida medium for presumptive identification of Candida yeast species and detection of mixed fungal populations
📄 Publication1994
CHROMagar Candida, a new differential isolation medium for the presumptive identification of clinically important Candida species
📄 Publication

Read more